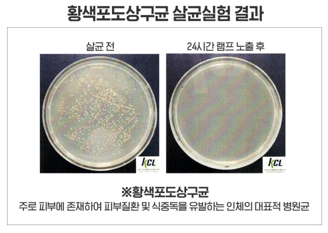

Đèn LED diệt khuẩn Hàn Quốc
Diệt vi khuẩn và vi trùng
Môi trường xung quanh chúng ta luôn tồn tại những vi trùng, vi khuẩn. Nhiều loại trong số chúng gây hại cho sức khỏe của con người. Trong một số không gian kín và có nguy cơ nảy sinh nhiều vi trùng, vi khuẩn và là mầm bệnh đối với chúng ta. Việc loại bỏ những vi trùng, vi khuẩn có hại này để đảm bảo vệ sinh, sức khỏe là cần thiết và quan trọng. Nhất là từ khi virus Corona (SARS-COVI-2) đã gây nên dịch bệnh toàn cầu từ đầu năm 2020.
Một phương pháp mới được dùng để khử khuẩn gần đây đó là dùng ánh sáng có bước sóng không gây hại cho cơ thể con người, ví dụ như ở bước sóng 405nm với ánh sáng xanh dương để bất hoạt các loại vi trùng, vi khuẩn trên bề mặt vật thể.


Đèn LED diệt khuẩn ánh sáng xanh được nghiên cứu, phát triển từ công nghệ chiếu sáng khử khuẩn hiện đại từ Hàn Quốc, sử dụng ánh sáng có bước sóng 405nm không gây hại cho con người. Sản phẩm được sản xuất tại Hàn Quốc và đạt chứng nhận của cơ quan chứng nhận an toàn của Hàn Quốc (chứng nhận KSC7653) và kết quả kiểm nghiệm diệt trừ vi khuẩn 99% trong vòng 24 giờ bởi Viện Nghiên Cứu Môi Trường Hàn Quốc.

Đèn LED diệt khuẩn có 3 chế độ chiếu sáng có thể thay đổi với chỉ 1 nút nhấn công tắc: chế độ chiếu sáng bình thường, chế độ chiếu sáng khử khuẩn cường độ cao, chế độ chiếu sáng khử khuẩn trung bình (để bớt gây khó chịu cho mắt). Đèn LED âm trần diệt khuẩn có thể dễ dàng thay thế cho các loại đèn downlight âm trần có cùng kích thước đang sử dụng trong nhà ở, văn phòng làm việc.


Đèn LED diệt khuẩn kiểu downlight âm trần có các công suất 11W (lỗ khoét 110mm) và 15W (lỗ khoét 145mm), hiệu suất chiếu sáng lên đến 100lm/W, vừa tiết kiệm điện lại đảm bảo an toàn vệ sinh cho môi trường sinh sống và làm việc. Đèn phù hợp lắp đặt tại các không gian như: nhà tắm, nhà vệ sinh công cộng, phòng làm việc, hành lang,..
Đèn LED diệt khuẩn Hàn Quốc còn có dạng gắn tường tiện lợi công suất 25W lắp đặt đơn giản.




Mọi chi tiết về sản phẩm đèn LED diệt khuẩn, vui lòng liên hệ Công Ty TNHH Ecolux để được tư vấn thêm. Hotline: 0926966922.





